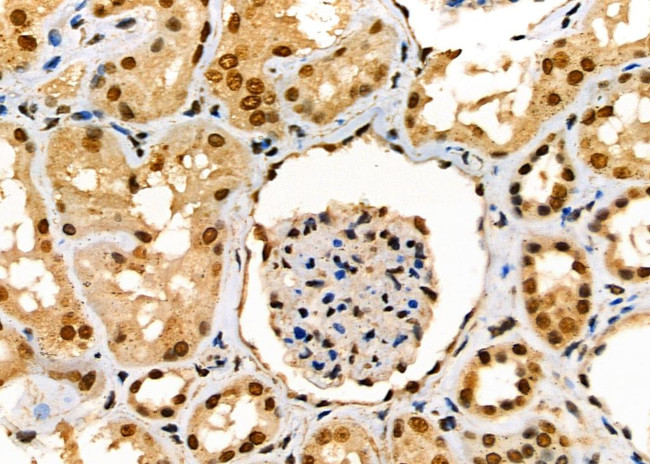
SCNN1G Antibody in Immunohistochemistry (Paraffin) (IHC (P))

Search
Invitrogen
SCNN1G Polyclonal Antibody
{{$productOrderCtrl.translations['antibody.pdp.commerceCard.promotion.promotions']}}
{{$productOrderCtrl.translations['antibody.pdp.commerceCard.promotion.viewpromo']}}
{{$productOrderCtrl.translations['antibody.pdp.commerceCard.promotion.promocode']}}: {{promo.promoCode}} {{promo.promoTitle}} {{promo.promoDescription}}. {{$productOrderCtrl.translations['antibody.pdp.commerceCard.promotion.learnmore']}}
图: 1 / 3
SCNN1G Antibody (PA5-103130) in IHC (P)



Please note: We are reviewing Western blot images included in the antibody testing data in our catalog, including those provided by third parties. Unless expressly labeled or annotated as “raw-unedited”, Western blot images included in the antibody testing data in our catalog may have been edited, optimized or otherwise adjusted for presentation.
产品信息
PA5-103130
种属反应
宿主/亚型
分类
类型
抗原
偶联物
形式
浓度
规格
纯化类型
保存液
内含物
保存条件
运输条件
RRID
产品详细信息
Antibody detects endogenous levels of total ENaC gamma.
靶标信息
Epithelial sodium channels are amiloride-sensitive members of the degenerin/epithelial sodium channel (Deg/ENaC) superfamily of ion channels. Members of this superfamily of ion channels share organizational similarity in that they all possess two short intracellular amino and carboxyl termini, two short membrane spanning segments, and a large extracellular loop with a conserved cysteine-rich region. There are three homologous isoforms of the ENaC (alpha, beta, and gamma) protein. ENaC in the kidney, lung, and colon plays an essential role in trans-epithelial sodium and fluid balance. ENaC also mediates aldosterone-dependent sodium reabsorption in the distal nephron of the kidney, thus regulating blood pressure. ENaC is thought to be regulated, in part, through association with the cystic fibrosis transmembrane conductance regulator (CFTR) chloride ion channel. Gain-of-function mutations in beta- or gamma-ENaC can cause severe arterial hypertension (Liddel's syndrome) and loss-of-function mutations in alpha- or beta-ENaC causes pseudohypoaldosteronism (PHA-1).
仅用于科研。不用于诊断过程。未经明确授权不得转售。
篇参考文献 (0)
生物信息学
蛋白别名: amiloride sensitive sodium channel gamma1 subunit; amiloride-sensitive epithelial sodium channel gamma subunit; amiloride-sensitive sodium channel gamma-subunit; Amiloride-sensitive sodium channel subunit gamma; ENaC gamma; ENaC gamma subunit; ENaC subunit gamma; Epithelial Na(+) channel subunit gamma; epithelial sodium channel gamma subunit; Epithelial sodium channel subunit gamma; Gamma ENaC; Gamma NaCH; Gamma-ENaC; Gamma-NaCH; nasal ENaC; hnENac; Nonvoltage-gated sodium channel 1 subunit gamma; PHA 1; SCNEG; SCNN 1G; sodium channe epithelial 1 gamma subunit; sodium channel epithelial 1 gamma subunit; Sodium channel epithelial 1 subunit gamma; Sodium channel nonvoltage-gated 1 gamma (epithelial); sodium channel, non-voltage-gated 1, gamma subunit; sodium channel, nonvoltage-gated 1, gamma; Sodium channel, nonvoltage-gated 1, gamma (epithelial); sodium channel, nonvoltage-gated, type I, gamma
基因别名: [g]ENaC; BESC3; ENaC; ENaCg; ENaCgamma; LDLS2; PHA1; PHA1B3; RCNaCh2; SCNEG; SCNN1G
UniProt ID: (Mouse) Q9WU39, (Rat) P37091
Entrez Gene ID: (Human) 6340, (Mouse) 20278, (Rat) 24768